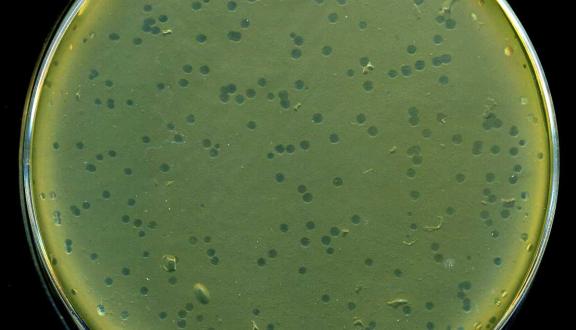

Laura Mosca

Laureata in Biologia Molecolare e PhD in Translational and Molecular Medicine presso l’Università di Milano-Bicocca. Ha lavorato presso il Dipartimento di Scienze Cliniche e di Comunità dell’Università degli Studi di Milano e il laboratorio di Biologia Molecolare dell’Ospedale Maggiore Policlinico di Milano partecipando a studi relativi alla caratterizzazione molecolare di neoplasie oncoematologiche. Collabora come scientific writer presso alcune riviste online in ambito salute e benessere.